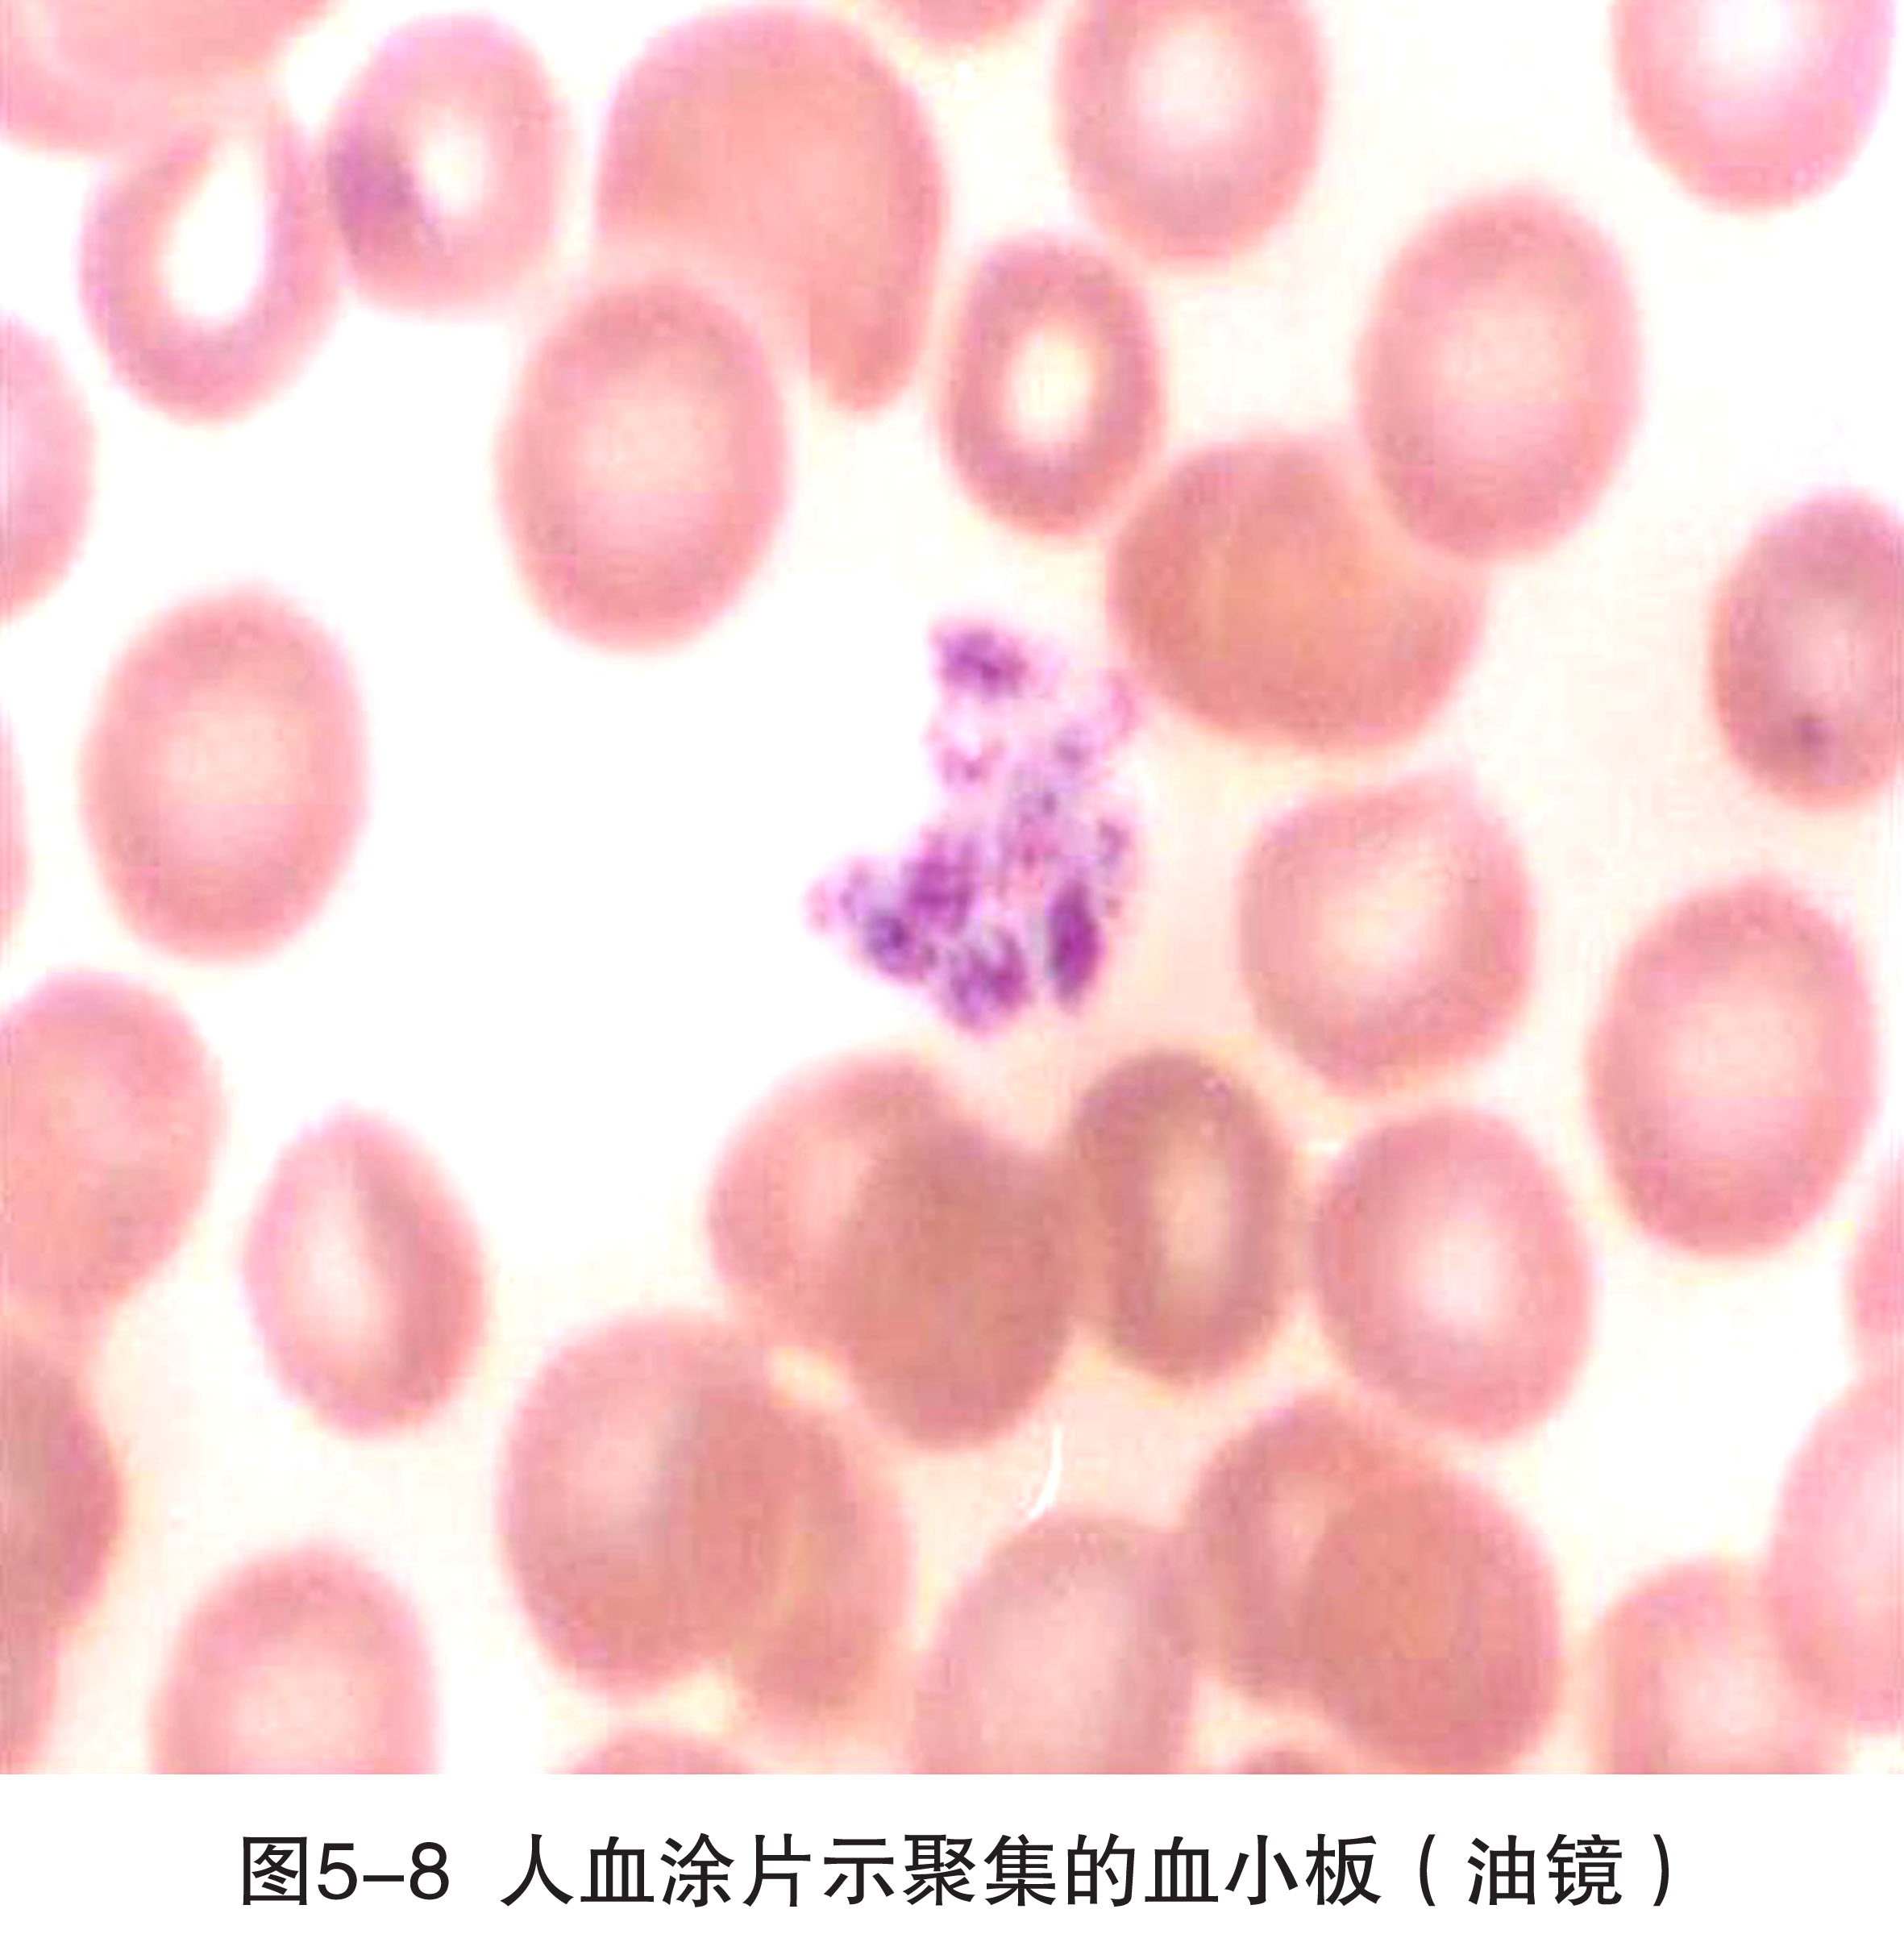
图5-8.jpg

血小板(blood platelet)是从骨髓巨核细胞脱落下来的胞质小块,并非严格意义上的细胞,故无细胞核,表面有完整的细胞膜。血小板体积甚小,直径2~4μm,呈双凸圆盘状;当受到机械或化学刺激时(如粘附于玻片),则伸出突起,呈不规则形。在血涂片上,血小板成群分布于血细胞之间。血小板中央部有蓝紫色的血小板颗粒,称颗粒区(granulomere);周边部呈均质浅蓝色,称透明区(hyalomere)(图5-8)。
电镜下,血小板表面吸附有血浆蛋白,其中有多种凝血因子。透明区含有微管和微丝,参与血小板形状的维持和变形。颗粒区有特殊颗粒、致密颗粒和少量溶酶体。特殊颗粒又称α颗粒,体积较大,圆形,电子密度中等,内含血小板因子Ⅳ、血小板源性生长因子(platelet derived growth factor,PDGF)、凝血酶敏感蛋白(thrombospondin)等。致密颗粒较小,电子密度大,内含5-羟色胺、ADP、ATP、钙离子、肾上腺素等。血小板内还有开放小管系统和致密小管系统。开放小管系统的管道与血小板表面胞膜连续,借此可增加血小板与血浆的接触面积,利于摄取血浆物质和释放颗粒内容物。致密小管系统是封闭的小管,管腔电子密度中等,能收集钙离子和合成前列腺素等(图5-9)。
血小板参与止血和凝血。当血管受损伤破裂时,血小板迅速粘附、聚集于破损处,凝固形成血栓,堵塞裂口,甚至小血管官腔。在这一过程中,血小板释放颗粒内容物,使血浆内的凝血酶原变为凝血酶,此酶促进纤维蛋白原变形成纤维蛋白,使血液凝固成血块而止血。此外,血小板还可保护血管内皮、参与内皮修复。血小板寿命约7~14天。


